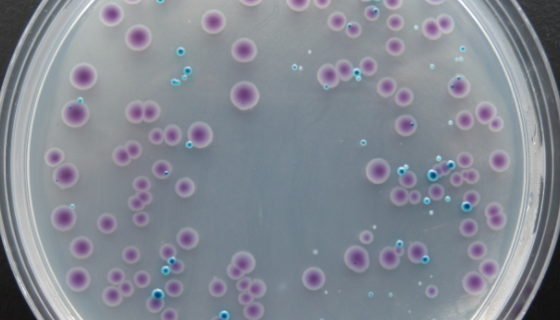
弧菌显色培养基的背景与应用及操作步骤！
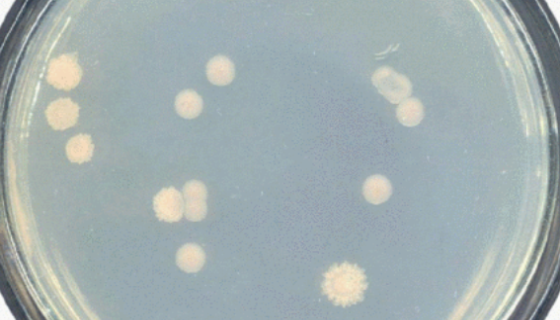
ATCC 25978 欧洲亚硝化单胞菌 百欧博伟生物
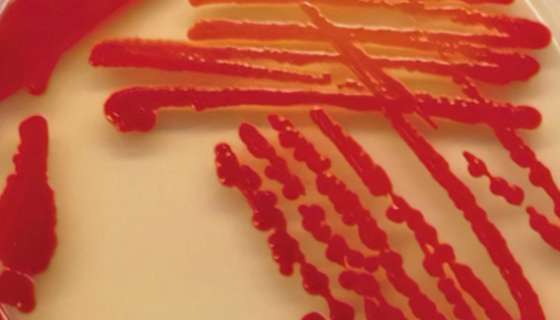
ATCC 183 普利茅斯沙雷氏菌冻干管打管说明！

人视网膜Muller细胞接收后的处理方法与注意事项!
Muller细胞是哺乳动物视网膜胶质细胞中重要的一种,结构上...
弧菌显色培养基的背景与应用及操作步骤!
弧菌显色培养基用于弧菌的显色培养,副溶血性弧菌显蓝色,霍乱弧...

猪心肌成纤维细胞的运输和保存及使用方法!
心脏是脊椎动物身体中最重要的一个器官,主要功能是提供压力,把...

杀鲑诺卡氏菌的培养方法与注意事项及打管说明!
杀鲑诺卡氏菌是Nocardia属的微生物,原产地为中国。革兰...
ATCC 25978 欧洲亚硝化单胞菌 百欧博伟生物
欧洲亚硝化单胞菌,硝化杆菌科内的一属。革兰氏阴性、细胞椭圆状...

D341 Med人髓母细胞瘤细胞收到后处理及其培养!
人髓母细胞瘤细胞仅用于科学研究或者工业应用等非医疗目的不可用...

德氏乳杆菌保加利亚亚种——生产研究和发酵酸奶
德氏乳杆菌保加利亚亚种是Lactobacillus属的微生物...
ATCC 183 普利茅斯沙雷氏菌冻干管打管说明!
普利茅斯沙雷氏菌是Serratia属的微生物,原产地为中国。...

人恶性黑色素瘤细胞接收后的处理方法与培养步骤!
人恶性黑色素瘤细胞接收后的处理方法与培养步骤及注意事项有哪些...